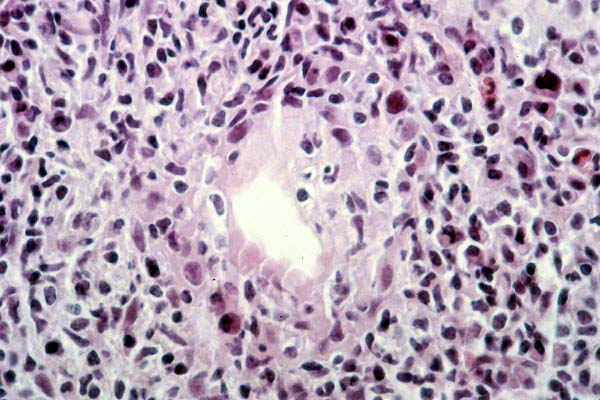
fig. 4

Póster
Nş 040
Póster |
Juan C. Tardío.
 |
| Figura 1.- Espacio porta ocupado por infiltrado inflamatorio, con lesión de un ducto biliar interlobular e imágenes de necrosis erosiva. |
 |
| Figura 2.- Espacio porta con infiltrado inflamatorio polimorfo dispuesto en torno a un ducto biliar interlobular. Obsérvese la presencia de un granuloma epitelioide. |
 |
| Figura 3.- Ducto biliar interlobular rodeado por infiltrado inflamatorio y con linfocitos en su pared. |
|
| Figura 4.- Ducto biliar interlobular con poliseriación y eosinofilia del epitelio, permeado por células inflamatorio. |
 |
| Figura 5.- Ducto biliar interlobular rodeado por una fibrosis concéntrica en capas de cebolla. |
 |
| Figura 6.- Infiltrado linfocitario lobular parcheado asociado a necrosis hepatocitarias aisladas. |